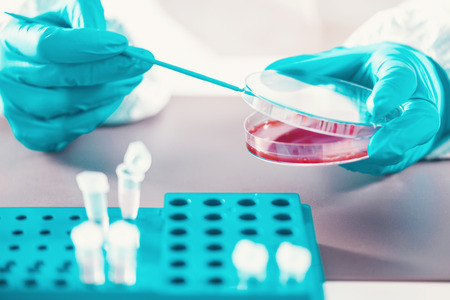
Microbiology, working with petri dishesの写真素材

写真素材 - Microbiology, working with petri dishes
キーワード
- Petri
- Petri dish
- agar
- analysis
- analyzing
- antibiotics
- bacteria
- bacterium
- biochemistry
- biology
- biotechnology
- blood
- chemist
- chemistry
- clinical
- colony
- culture
- diagnosis
- discovery
- education
- equipment
- experiment
- female
- growth
- hands
- human hand
- in vitro
- infection
- lab
- laboratory
- medical
- medicine
- microbial
- microbiologist
- microbiology
- mrsa
- research
- researcher
- researching
- resistance
- sample
- science
- scientific
- scientist
- technology
- test
- unrecognizable
- woman
類似作品
Lots of dirty d...
Laboratory for ...
Science and Lif...
petri dish fill...
Close-up of pet...
A cluster of va...
Bacteria or mic...
Close-up detail...
Bacterial cultu...
Petri dishes in...
A vivid close-u...
Macro close up ...
Hands of a scie...
petri dish with...
Petri dish with...
Hand with a glo...
Laboratory petr...
Backgrounds of ...
epidemic and th...
bacteria colony...
Mixed of bacter...
A close-up view...
detail of bacte...
Exploring vibra...
bacteria colony...
Macro close up ...
bacteria colony...
Chemical Labora...
Detailed view o...
Colorful variet...
Female scientis...
Colony of bacte...
Backgrounds of ...
A clear glass d...
microbiology la...
Abstract backgr...
Macro close up ...
Bacteria and mi...
Researchers wor...
Fresh and vibra...
microbial cultu...
Scientist pipet...
Team Asian scie...
Team Asian scie...
Bacteria growin...
Scientist using...
Scientist worki...
Fresh fruits an...
A microbiologis...